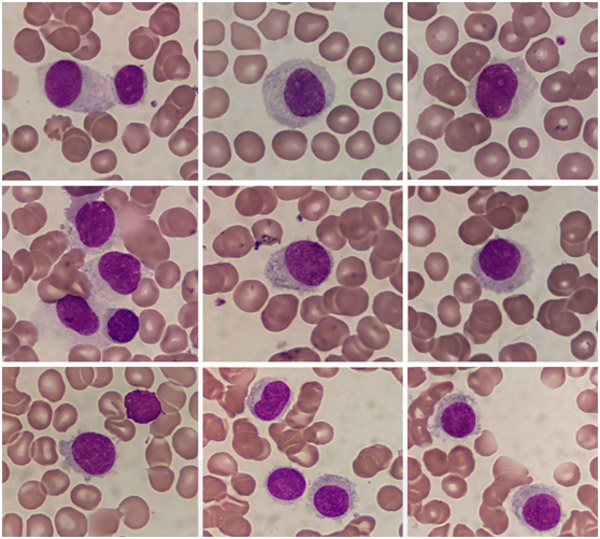

白血病是常見病、多發病,早期發現、早期診斷和早期治療對白血病預后非常重要。隨著檢驗技術的發展,細胞形態學、免疫學、細胞遺傳學和分子生物學等技術的綜合運用對白血病的早期準確診斷具有舉足輕重作用。
2021年4月,嚴先生在當地醫院體檢時發現血小板計數94×109/L,當時并無任何不適癥狀,所以也沒有太在意。一個月后,他發現右前臂大片紅色瘀點,無瘙癢,持續半天后自行消失,這樣的癥狀時有發生,為求進一步診治,近期患者來到了柳州市人民醫院,門診以“血小板減少查因”收入血液內科。

入院后醫生對嚴先生進行了各項檢查,發現患者血常規結果提示血小板減少,單核細胞增多,醫學檢驗科立即又進行了血涂片及骨髓片鏡檢,兩片鏡下均發現一類細胞胞體中等,多類圓形;胞核多圓形,偶見凹陷,染色質纖細疏松;胞漿量多,灰藍色或淡藍色,偶見空泡,邊緣有絨毛突起,形如“煎雞蛋”。

這種形如“煎雞蛋”的細胞在血細胞形態學中常指多毛細胞,其本質是病理性B淋巴細胞,其胞漿邊緣多有絨毛狀突起,常累及外周血、骨髓及脾臟,引起的疾病稱為多毛細胞白血病(hairy cell leukemia,HCL),它是一種罕見的慢性淋巴細胞增殖性疾病,約占淋巴系統腫瘤2%,本病的主要臨床特征為全血細胞減少和脾大,但其起病隱匿,臨床表現復雜多樣,極易被漏診和誤診,進而影響治療效果與預后。
為了進一步確認鑒別診斷,又為患者進行了骨髓活檢、免疫分型及BRAF V600E基因等有關于多毛細胞白血病方面的檢查,最終結合臨床、病理活檢、免疫學、遺傳學及分子生物學等一系列復雜的檢查,幫助病人明確病因,確診為多毛細胞白血病,為臨床治療提供了有力的依據。

每當診斷罕見或疑難病例后,醫學檢驗科骨髓細胞室均及時整理病例資料,與血液內科、病理科及流式細胞的專家們進行探討,通過一個病例的診斷討論、分享討論再到總結學習,助力臨床的同時,時刻提高自身能力,為廣大患者提供更優質準確的醫學檢驗服務。